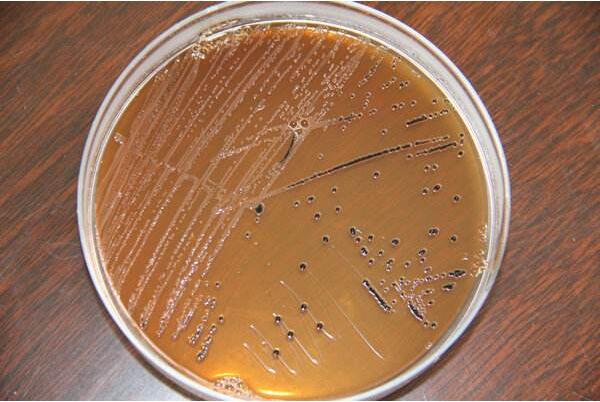

【多發性膽囊息肉吃什麼好】
文章分類:生活養生
你也會想看的:7招教你如何抗衰老
多發性膽囊息肉的危害可表現為,患者平時訴腹脹等消化不良癥狀,急性發作時,主要表現為右上腹或上腹部疼痛,伴有惡心、嘔吐,甚至發熱等。還可能出現很多嚴重的並發癥:膽囊壁壞死、穿孔、繼發膽總管結石、急性胰腺炎等。
多發性膽囊息肉如何註意飲食
而多發性息肉多數是由膽囊壁上皮細胞的基底膜內有膽固醇沉積的膽固醇沉著癥,它是膽囊的良性病變,很少發生癌性改變。大多數膽囊多發息肉的癥狀與慢性膽囊炎相似,主要表現為右上腹輕度不適,伴有結石時可出現膽絞痛,但也有相當數量的患者並無癥狀,大約有5%以上的患者都是在例行體檢中發現。在檢查上,3~4mm以下的息肉在CT和核磁共振中難以發現或常常


